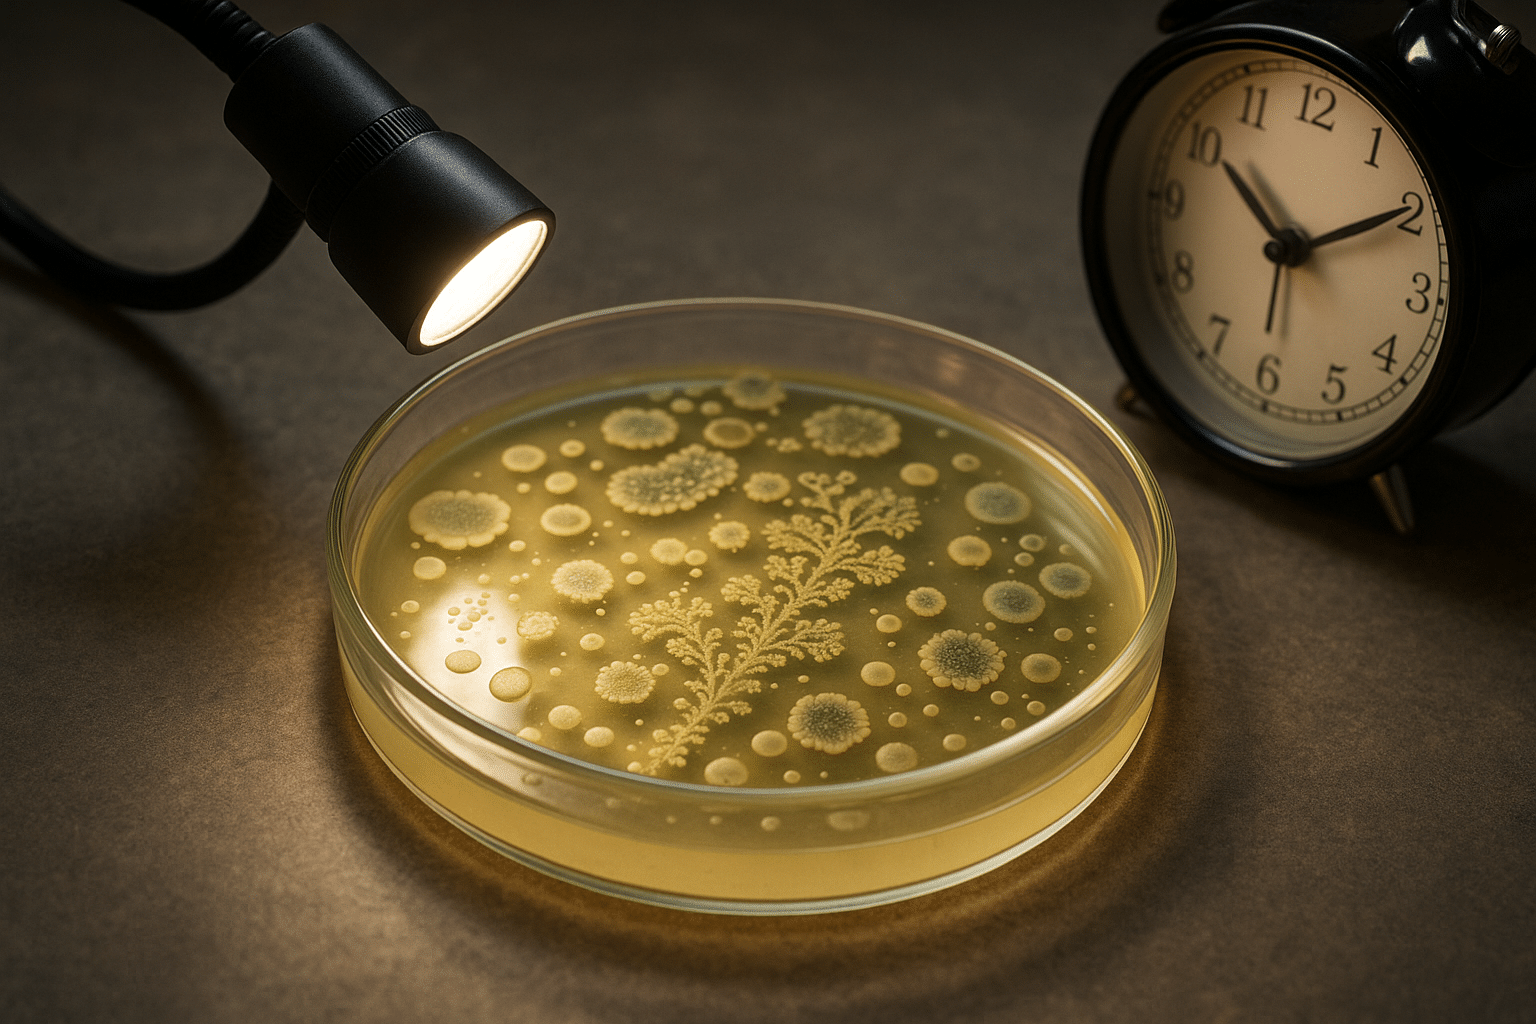

Microbial Rivalry Sparks Innovation
Microbial ecosystems reveal powerful lessons about competition, adaptation, and innovation that can reshape how we approach creativity and problem-solving in human endeavors. 🦠 The Hidden World of Microbial Warfare Beneath our feet, in the soil we walk on, and within our own bodies, exists a microscopic universe engaged in constant competition. Microorganisms—bacteria, fungi, archaea, and … Ler mais